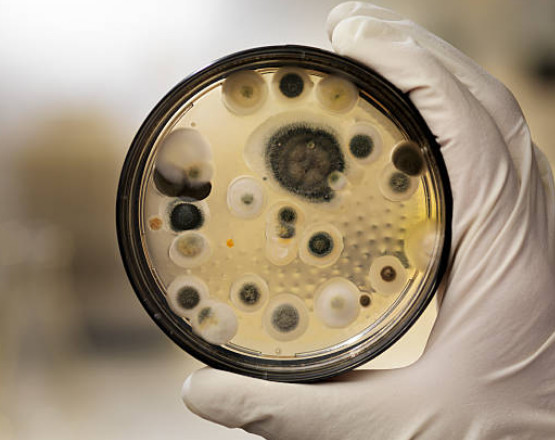

곰팡이 제거방법 관리방법 예방법 총정리
홍수, 장마, 태풍 등의 자연재해 후 높은 습도와 고인 물은 주택과 건물에 곰팡이 발생을 유발할 수 있으며, 이로 인해 우리의 건강이 위험해질 수 있습니다. 오늘은 이러한 곰팡이로부터 우리를 보호하기 위해 곰팡이 제거방법 관리방법 예방법에 대해서 자세히 살펴보도록 하겠습니다.

곰팡이란?
곰팡이는 어둡고 습한 환경에서 자라는 미세한 실 모양의 미생물입니다. 현재까지 알려진 곰팡이 종은 약 72,000종으로, 생물계에서 식물과 곤충을 제외하면 가장 다양한 종을 가지고 있는 그룹 중 하나입니다. 곰팡이는 습한 환경, 충분한 수분, 적절한 온도, 약간의 영양분만 있으면 음식물, 식물, 벽, 바닥 등 다양한 표면에서 자라날 수 있습니다. 따라서 적절치 않은 습도와 온도 관리, 청결하지 않은 환경은 곰팡이 성장에 적합한 조건을 제공할 수 있습니다.
알레르기, 천식, 만성 호흡기 질환을 가진 사람들은 곰팡이에 민감할 수 있습니다. 또한, 항암 치료나 장기 이식을 받은 환자, 그리고 면역 억제 상태에 있는 사람들은 곰팡이에 쉽게 감염될 수 있습니다. 곰팡이에 민감한 사람들은 코 막힘, 눈 가려움증, 호흡 곤란, 피부 자극과 같은 증상을 경험할 수 있습니다. 또한, 곰팡이 알레르기 반응을 나타내는 사람들도 호흡곤란과 숨 막힘과 같은 증상을 겪을 수 있습니다. 면역체계가 약한 사람들이나 만성 폐질환을 가진 사람들은 폐에서 곰팡이 감염을 겪을 가능성이 있습니다. 때문에 이러한 증상이 곰팡이 노출 후에 발생하면, 의료 전문가와 상담하는 것이 좋습니다.


곰팡이 제거방법
곰팡이 제거방법 ① 일반적인 곰팡이
딱딱한 표면에서 곰팡이를 제거하려면 시중에 판매되는 곰팡이 제거용 제품을 사용하거나, 약 3.8리터의 물에 1컵 이하의 표백제를 혼합하여 사용합니다. 고르지 않은 표면 재질인 콘크리트와 같은 경우에는 단단한 솔을 사용하여 곰팡이를 제거할 수 있습니다.


곰팡이 제거방법 ② 화장실 곰팡이
건조제(실리카겔)를 김, 약, 과자봉지 등에서 수집하여 부직포 주머니에 넣은 후 욕실에 걸어두면 습기를 줄여 곰팡이 발생을 억제할 수 있습니다. 이미 곰팡이가 생긴 욕실 바닥의 경우, 헝겊에 소다를 푼 물을 적셔서 닦아주고, 소다와 식초를 혼합하여 사용하면 오래된 곰팡이 얼룩을 제거할 수 있습니다.


곰팡이 제거방법 ③ 주방 곰팡이
실리콘 이음새에 생긴 곰팡이를 제거하려면 락스나 곰팡이 제거제를 분무기에 담아 실리콘 부위에 뿌린 후, 티슈를 덮어두고 하루 동안 방치한 뒤 제거하면 됩니다.
곰팡이 제거방법 ④ 에어컨 곰팡이
에어컨 필터는 칫솔로 먼지를 제거한 다음 전용 클리너를 사용하여 세척합니다. 이후 깨끗하게 세척한 에어컨 필터를 바람이 잘 통하는 곳에서 말려두고 사용합니다. 에어컨의 날개도 작은 빗자루로 먼지를 털어내고 걸레로 닦아 관리합니다. 소다를 물에 희석시켜 걸레에 묻혀 사용하면 더 효과적입니다.


곰팡이 제거방법 ⑤ 세탁기 곰팡이
세탁기 내부의 곰팡이를 제거하는 방법 중 하나로, 시중에 판매되는 세탁조 곰팡이 제거제를 사용할 수 있습니다. 또한, 세탁기에 뜨거운 물을 가득 부어서 세제나 빙초산 300ml 정도를 넣어 반나절 동안 두었다가 일반 세탁 모드로 돌려서 곰팡이를 제거할 수 있습니다. 드럼세탁기를 사용하는 경우, 드럼 전용 세정제를 사용하고 삶기 모드로 실행하여 곰팡이를 쉽게 제거할 수 있습니다. 이러한 과정을 1년에 3~4회 정도 수행하면 좋습니다.


곰팡이 제거방법 ⑥ 의류 곰팡이
한 번 곰팡이로 손상된 섬유를 완전히 원래 상태로 되돌리는 것은 어렵습니다. 곰팡이가 생긴 의류의 경우, 락스와 소다를 물에 희석하여 곰팡이 부분에 담가두면 얼룩을 제거할 수 있습니다.
참고: 고급 섬유나 색상이 있는 의류에는 사용하지 말아야 합니다.
곰팡이 제거 시 표백제 사용 유의사항
곰팡이 제거를 위해 표백제를 사용하려면 주의가 필요합니다. 특히 암모니아가 첨가된 표백제는 유독 가스 발생의 위험이 있으므로 사용을 피해야 합니다. 추가로, 다음 조치를 취할 수 있습니다.
▶신선한 공기 환기를 위해 창문과 문을 열어주세요.
▶구멍이 없는 장갑과 안전 안경을 착용하세요.
▶표백제나 청소용품을 사용할 때는 제조업체의 지침을 엄수하세요.
▶자연재해 이후 청소를 진행할 때 개인 안전에도 신경 써야 합니다.
▶곰팡이를 청소하거나 곰팡이 피해가 예상되는 건물 내부에 있을 때는 마스크를 착용해야 합니다. 마스크는 얼굴에 밀착되도록 착용되어야 합니다.

곰팡이 관리방법 및 예방법
▶만일 집안에서 곰팡이가 생겼다면, 먼저 곰팡이를 제거하고 집 안의 배관, 벽, 지붕 등에서 누수 문제가 없는지 확인해야 합니다. 습기를 집 안에서 효과적으로 관리하는 것이 곰팡이 성장을 방지하는 데 중요합니다.
▶집이나 건물 외벽, 수도 배관 등에서 물이 새는 지점을 확인하고 이러한 문제를 빠르게 수리해야 합니다.
▶온도차이로 인해 창문 등에 습기가 생기지 않도록 예방하는 조치를 취합니다.
▶제습기나 에어컨과 같은 기기를 사용하여 실내의 온도와 습도를 유지하려고 노력합니다.
▶곰팡이의 영양원이 될 수 있는 먼지나 다른 물질을 정기적으로 청소하고 주변 환경을 청결하게 관리합니다.
건물 또는 집 침수 시 대처법
▶곰팡이가 생겼다면 24~48시간 이내에 청소하고 아주 잘 말리도록 합니다.
▶문과 창문을 열어 환기시킵니다.
▶선풍기를 활용하여 실내를 건조하게 합니다.
▶충분히 건조되지 않은 물품은 버립니다.
▶완전한 청소와 건조가 어려운 다공성 물건은 48시간 이상 습기가 유지되어 있으면 버려야 합니다. 이러한 물건은 곰팡이 성장의 원인이 될 수 있으므로 집 안에 두지 말아야 합니다.
▶다공성이면서 효과적인 청소나 건조가 어려운 물품으로는 카펫류, 카펫 패딩, 덮개, 벽지, 석고판, 바닥 및 천장 타일, 단열재, 흠뻑 젖은 두꺼운 옷, 가죽, 종이, 나무, 식품 등이 포함됩니다.
지금까지 곰팡이 제거방법 관리방법 예방법에 대해서 자세히 알아보았습니다. 도움이 되셨기를 바랍니다. 읽어주셔서 감사합니다.